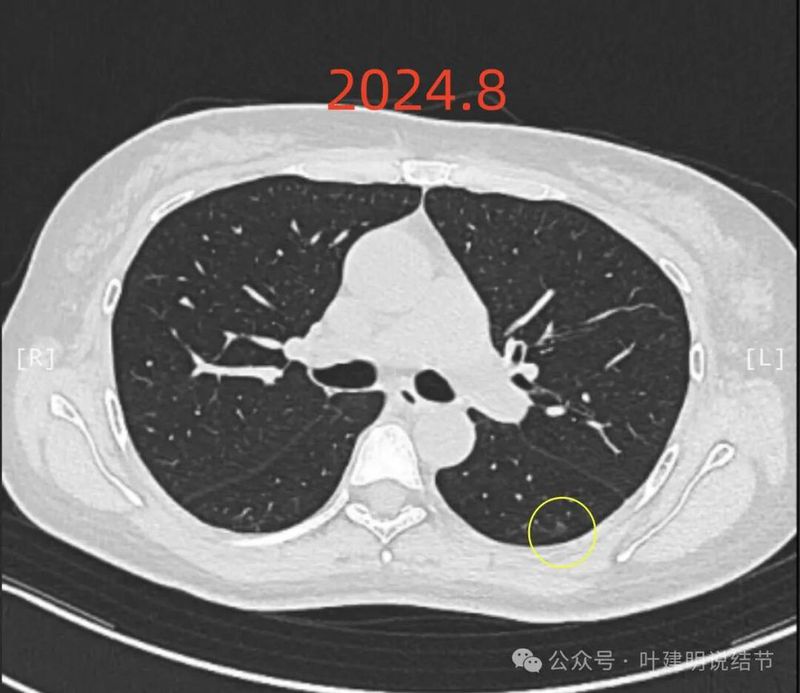
图片
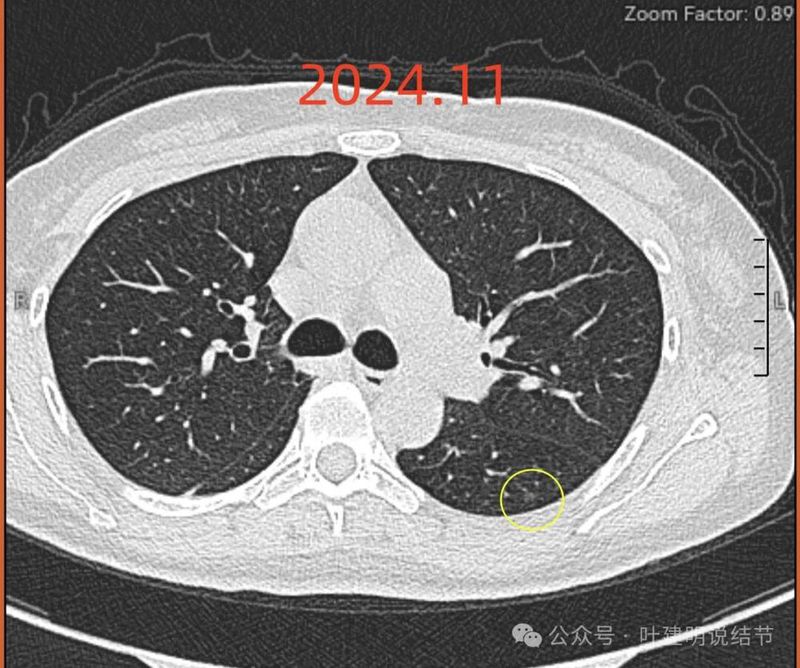
图片

前言:肺癌术后新现结节,很多时候医生都会带上一句“转移不能除外”或者“需要考虑转移可能性”等,从而给患者带来无比的焦虑与不安。尤其是手术当时若是告诉其是早期肺癌的,而不久后又说怀疑转移,那是怎样的崩溃与不解!实际上,医生在不把话说死,虽是为了避免带来误诊或漏诊的的风险,但也要从前后对比与综合考虑评估,尽量不要给患者增加过度的不安与思想负担。这难道不也是医生该负起来的责任吗?“凡是既不肯定,也不否定,从而让患者自己去猜,要明确就得切了化验”这样的态度虽看着天衣无缝,但绝非是真正以患者为中心考虑问题的医生所该秉持的态度。
病史信息:
基本信息:
女性,50岁 。
主诉:
发现肺结节10个月,肺结节切除术后4个月。
现病史:
患者于2024年2月份发现实性结节,8月手术,病理中分化腺癌,中分化1a期,医生说无需后续治疗,未曾辅助治疗,11月复查ct发现左下肺一实性结节(2月尚无,5月开始出现,后逐月增大),直径4.66mm,怀疑是肺内转移。
疾病描述:
叶医生您好,2024.2.29某市级医院A医院体检发现实性结节后,到处问诊,各医生对22年和23年是否已有此结节说法不一,大多考虑炎性病灶,5月A医院复查变化不大,10*8毫米,就继续随访;7.29俯卧位+重建发现明显大了,达14*7毫米,比较慌,并且找出来了23年12月因背痛做的ct,7毫米左右,基本确定恶性。2024.8月入住某省级医院B医院,增强ct14*7毫米,petct1.02,结论仍偏向炎性病灶。2024.11月复查后发现较5月有新增一实性结节,并且逐月增大变实,考虑肺内转移。询问病理科医生说我有部分粘液性,由于不到10%所以没报,这似乎能解答了免疫组化异常,易与炎性混淆,和pet代谢不高的疑问,可惜问诊近10个月,没有任何人考虑到过这个可能,每天过的如履薄冰,尤其11月复查后考虑转移瘤,直接治愈变晚期,完全无法正常生活了,不知道何去何从,最近看到了叶医生的科普文章,恳请叶医生能帮忙重新梳理下,指导下我下一步该如何,谢谢。
希望获得的帮助:
多谢!
影像展示与分析:
先看2024.2初发现时右下主病灶的情况:

病灶出现,密度较淡,膨胀性不明显,整体轮廓较清。

密度有增高,基本上实性,边缘较为平直,缺乏膨胀性或收缩力。

实性密度,边缘较平直。

前侧有血管贴边,但没有明显牵拉,后侧边缘欠平整。

实性密度,表面不光滑,缺乏膨胀性或收缩力。

边缘区也是实性密度。
回顾右下主病灶既往以及后续随访情况:

2022年5月时右下此处没有异常。

其实2023年12月体检时已经有了,但显然缺乏恶性的影像特征,整体并无收缩力或膨胀性。

2024年2月时已经较前有所增大进展,边缘显得毛糙。

2024年7月时又有增大进展了。
再看2024年8月连续层面右下主病灶的情况:

病灶出现,实性密度。

密度较高,中间似不太密实。

部分边缘有类似月牙铲征,表面有的区域似有浅分叶,灶内不够密实。

实性伴灶内小空泡,表面不平,部分边缘有毛刺。

表面不平,血管贴近。

实性结节,轮廓清楚,灶内小空泡可扩张细支气管。

部分边缘有细毛刺样征。
PET-CT检查报告:

PET报告提示右下结节代谢稍增高,炎性增殖病变较肿瘤可能性大。
主病灶手术病理结果:
病理结果确诊是浸润性腺癌,腺泡型,中分化。
左侧新增病灶的前后情况:

2023.12左下背段微小磨玻璃结节(病灶A),轮廓与边界清,有微小血管贴边或穿行,考虑肺泡上皮增生或不典型增生可能性大。

回顾看2023年12月时左下后来出现实性结节的地方,当时也是有异常的,微小偏实性结节(病灶B)。当然太小,没法定性质,除了密度略显得有点高以外,也看不出良恶性的影像特征来。

2024年7月时病灶A仍在,且无明显进展。

病灶B较前似稍明显点,仍小且轮廓清。

病灶B局部放大看,好像有部分是磨玻璃成分的,部分是实性密度的。整体轮廓与边界较清。
2024年8月时病灶A似乎较前面显得淡了点。

病灶B仍是很小。

病灶B局部放大看,实性部分密度过高,磨玻璃部分密度较淡。
到了2024年11月,病灶A仍是淡磨且微小。

病灶B整体都变实性了,轮廓与边界清。

局部放大看,病灶B基本上都变成了实性,而且密度较高,有见到微小血管走向病灶。
我的意见:
右下主病灶单次看确实缺乏典型恶性的影像特征,好在有随访对比资料,从而明确它是不断进展的,所以正确的做了手术的决定。回头再看此灶,边缘不平有毛刺(不太锐利),与邻近血管之间也没有间隙,还确实是需要提高警惕的,至少不能简单认为是慢性炎或良性,需要重点关注对比的。至于左下新现的实性小结节,我对比了历次的影像资料,回头看此结节也是极微小不明显,后发展到混合密度,再到实性密度,确实也算进展的。但一是这病灶太小,二是密度高或有进展也不能就认定是转移灶。这几年呼吸道感染的很多很常见,我也碰到过许多例肉芽肿随访进展的,所以此结节若是炎性的,进展同样能解释。关键是若换个角度讲,此结节即使真的是转移,那是血行转移,等它再大点或再确切些再予以治疗与现在就按肺癌晚期治疗,预后能有多少差别?但若其实是良性,对于早期肺癌,本不必辅助治疗的,你把靶向治疗、化疗或免疫治疗都用上,对机体长久来说,到底是有好处,还是有弊端?这都难说。左下背段报告上说的磨玻璃结节,非常小也很淡,目前没有风险,也没有太大的临床意义。个人总体倾向不要在意这种过小的结节是不是转移,或是不是恶性,先按早期肺癌术后的频率随访,若原定半年复查的,也可先按4个月复查,几年下来稳定再延长到半年复查。随访过程中,真有再进展,一是左下实性灶不断进展增大,并达1厘米以上,现出典型转移瘤征象,二是他处新增实性结节也符合转移瘤。再来考虑后续全身性治疗的事情。关键是心态要摆正,接受生命的考验,不该过度解读与焦虑,因为我们无法改变既定的结局。也不能凡事都往最坏的方向考虑。意见供参考!
感悟:
左下实性结节到底是不是恶性,是不是转移?这目前下定论仍是不能够的。但我想从右侧主病灶中分化,腺泡为主伴部分粘液腺癌来讲,这么短时间内出现转移是不能解释的。但多原发早期肺癌的可能性反而可能性较转移更大点,一是由左下背段病灶A的存在,以及右侧主病灶是早期肺癌,说明致肿瘤发生的内因或机体的内外因作用仍是存在的;二是病灶B随访确实是进展的,加上右下主病灶当时影像表现也不典型,会不会类似的性质呢?它也表现不典型,这是可以的。再有一种可能是,病灶B并非恶性,而是慢性炎或肉芽肿性,也同样符合缓慢进展以及密度变高的过程,若再随访后钙化了,那更要考虑其实就是肉芽肿性炎。时间会给我们答案,我们其实不必对于早期肺癌术后的病人谈结节色变,不能总把自己想成是最不幸运的那一个!
